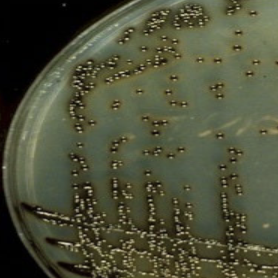
<p>which specialized media for corynebacterium diphtheriae isolation refers to forming black colonies from hydrolysis of tellurite?</p>
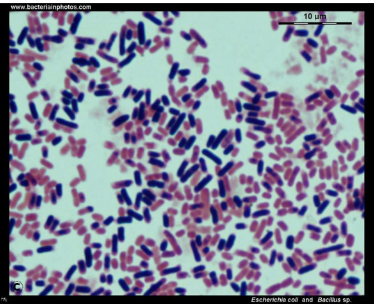
<p>which species has the following characteristics:</p><ul><li><p>gram stain: straight bacilli with square ends (“<strong>box-car</strong>”) in chains and singly </p></li><li><p>cultures: large, flat colonies “<strong>ground glass</strong>”</p></li></ul><p></p>

1/120
Looks like no tags are added yet.
Name | Mastery | Learn | Test | Matching | Spaced | Call with Kai |
|---|
No analytics yet
Send a link to your students to track their progress
the important clinical species of _____ include:
C. diptheriae
C. jeikeium
C. urealyticum
corynebacterium
other _____ species include the following:
part of normal flora of humans
usually (skin) contaminants, although some can cause disease in immunocompromised patients
“diphtheroids”
clinical labs do not speciate unless requested or thought to be clinically significant
corynebacterium
corynebacterium are anaerobic and grown on BAP (24 hours). true or false?
false
corynebacterium is non-motile. true or false?
true
corynebacterium is catalase ____.
positive

which species of corynebacterium is associated with the following:
Found only in humans
Identifying characteristics:
Gram Stain:
Gram Positive Rod
Non-spore forming
Pleomorphic: can be tapered, curved, or club-shaped (“koryne” is Greek for “club”)
“Chinese letters” or “picket fences” or palisades
corynebacterium diphtheriae
corynebacterium diphtheriae staining with methylene blue will reveal ____ (red-purple intracellular granules).
metachromatic granules
which bacteria is the cause of diptheria?
corynebacterium diphtheriae
which specialized media for corynebacterium diphtheriae isolation refers to forming black colonies from hydrolysis of tellurite?
cystine tellurite

which specialized media for corynebacterium diphtheriae isolation refers to forming brown-black colonies with halos from hydrolysis of tellurite?
tinsdale’s agar

which specialized media for corynebacterium diphtheriae isolation refers to enhancing formation of metachromatic granules where colonies will appear small, white/grey?
loeffler agar
which species of corynebacterium is associated with the following:
will grow happily on BAP in 24 hours
most are non-hemolytic
urease, pyramidase negative
nitrate, catalase positive
non-motile
corynebacterium diphtheriae
diphtheria is vaccine preventable (DPT). the vaccine the a formalin-treated toxin → ____.
toxoid
humans can be carriers of diphtheria. true or false?
true
the transmission of ____ include:
droplet
direct contact with cutaneous lesions
contact with fomites (rarer)
diphtheria
the production of ____ is necessary for pathogenicity as the cytotoxic features inhibit protein synthesis.
exotoxins
the structural gene for the diptheria toxin is contained in a ____ genome (tox gene).
bacteriophage
only strains that have been infected by ____ can produce the exotoxin that causes diphtheria.
bacteriophage
low ____ levels are associated with gene expression/virulence of diphtheria.
iron
the biotypes of _____ include intermedius, belfanti, mitis, and gravis.
diphtheria
the incubation of diphtheria is ____ days.
2-4
the presentation of ____ includes pharyngitis or tonsillitis which will include fever, malaise, and sore throat.
diphtheria
for diphtheria, a patch of exudate or _____ develops on the tonsils, uvula, soft palate, or pharyngeal wall.
membrane
which condition is associated with the following:
grey-white membrane
composed of fibrin, leukocytes, cellular debris
can extend down to the larynx and trachea
can have cervical adenitis and edema: “bullneck” appearance
diphtheria
other organisms can cause a ____ in the throat/over tonsils including streptococcus species, CMV, EBV, C. albicans, Arcanobacter haemolyticum.
membrane
_____ cases of diphtheria include membrane being coughed up after 5-10 days.
uncomplicated
_____ cases of diphtheria include mechanical respiratory obstruction from membrane, edema, and hemorrhage; it can be sudden and complete (suffocation) especially if large sections of membrane separate.
complicated
____ effects of the absorbed toxin for diphtheria include the following:
heart: myocarditis (cardiac enlargement/weakness, arrhythmia, congestive heart failure)-most common/serious
nervous system: paralysis of soft palate, eye muscles; generally reversible and not as serious unless diaphragm is involved
systemic
diphtheria is fatal in 5-10% of cases with higher mortality in young children. true or false?
true
the elek test tests for ____ production in isolates identified as C. diphtheriae.
toxin

what test is described:
strip of filter paper soaked with diphtheria antitoxin embedded in agar
isolates and + control, - control streaked onto agar surface
incubated 1-2 days
when diphtheria toxin reacts with antitoxin, a line of precipitate forms in the agar = toxigenic strain
elek test
C. diphtheria ____ testing detects the regulatory gene for toxin production (dtxR) and the diphtheria toxin gene (tox).
PCR
the organism/histopathologic dx must have both an isolate and an epidemiologic link to a known case to confirm ____.
diphetheria
which species of corynebacterium refers to the CDC group JK?
corynebacterium jeikieium
corynebacterium jeikieium is susceptible to many antibiotics. true or false?
false
corynebacterium jeikieium is pyazidamidase _____.
positive
corynebacterium jeikieium is ____, so it loves fat/lipids.
lipophilic
corynebacterium urealyticum is susceptible to antibiotics. true or false?
false
the immunocompromised are most at risk for ____ through UTIs and wounds.
corynebacterium urealyticum
which species of corynebacterium is rapidly urease positive?
corynebacterium urealyticum
which species of corynebacterium may be responsible for the formation of stones in the urinary tracts of some patients?
corynebacterium urealyticum
which species has the following characteristics:
large gram positive/gram variable rods
aerobic or facultatively anaerobic
grows on BAP and PEA (phenylethyl alcohol)
do not normally grow on agars for enterics (MAC, etc.)
spore-forming
spores can be central or terminally located
can survive adverse conditions for prolonged periods of time and are frequent contaminants of laboratory cultures
bacillus
which species has the following characteristics:
gram stain: straight bacilli with square ends (“box-car”) in chains and singly
cultures: large, flat colonies “ground glass”
bacillus
most species of bacillus are pathogenic. true or false?
false
what are the two species of bacillus that are pathogenic?
bacillus anthracis; bacillus cereus
which bacteria causes anthrax?
bacillus anthracis
which species of bacillus is considered a potential bioterrorism agent?
bacillus anthracis
bacillus species is catalase ____.
positive
which bacillus species has the following characteristics:
GPR with spores
catalase positive
non-motile
non-hemolytic
bacillus anthracis
which bacillus species has the following characteristics on a BAP:
filamentous projections “medusa head”
consistency of beaten egg whites: when the edge of the colony is lifted with a loop, the colony remains in an upright position
bacillus anthracis
bacillus anthracis can form “string of pearls” (chains of spherical bacilli) when incubated several hours on agar with ____.
penicillin
what condition is associated with the following:
zoonosis (usually found in herbivores: cattle, deer, etc.)
disease can spread via spores in pastures contaminated with exudates of infected animals
human infections are rare in the U.S.
contact with infected animals/animal products
mostly associated with imported animal products (wool/hides, bone/contaminated with fertilizer containing bone meal)
anthrax
bacillus anthracis is susceptible to ____ (cipro stockpile post 9/11).
penicillin
which clinical form of anthrax refers to the following:
most common form worldwide
incubation 2-5 days
invades skin, usually through unrecognized breaks
initially forms an erythematous papule, which could be mistaken for an insect bite
cutaneous anthrax
by day 7-10, cutaneous anthax may progress into a necrotic lesion known as ____, surrounded by edema (“malignant pustule” but neither malignant nor a pustule).
black eschar
what condition is pulmonary anthrax associated with?
woolsorter’s disease
which clinical form of anthrax refers to the following:
contracted by inhalation of spores
handling contaminated hides, hair, wool in a confined space
lab exposure
incubation 1 day
pulmonary anthrax
which clinical form of anthrax refers to the following:
initial symptoms (1-5 days)
nonspecific malaise, mild fever, nonproductive cough
progression:
progressive respiratory distress and cyanosis
massive edema of neck, chest, mediastinum
if untreated:
fatal outcome is usually rapid once edema has developed
enormous amounts of organisms can be found in lungs, blood, and all other organs
pulmonary anthrax
which clinical form of anthrax refers to the following:
ingestion of raw or inadequately cooked meat containing bacillus anthracis spores
can affect the upper GI tract (throat and esophagus), stomach, intestines
incubation: 1-7 days post exposure
untreated: 50% mortality
treated: 40% mortality
rarest form
gastrointestinal anthrax
which species of bacillus is associated with the following:
food poisoning
enterotoxin: 2 types
emetic
diarrheal
associated with fried rice and chinese food restaurants
mac and cheese from powdered milk
“meals on wheels”
bacillus cereus
which enterotoxin for bacillus cereus is associated with the following:
cereulide
short incubation period: 1-6 hours
nausea, vomiting, cramps (“emetic”)
heat tolerant and pre-formed
emetic
which enterotoxin for bacillus cereus is associated with the following:
longer incubation period: 8-16 hours
causes fluid excretions in the same manner as toxigenic E. coli and V. cholerae
diarrheal
which species of bacillus has a capsule?
bacillus anthracis
which species of bacillus is non-hemolytic?
bacillus anthracis
which species of bacillus is associated with the following toxin:
exotoxin (EF, PA, LF)
bacillus anthracis
which species of bacillus is associated with the following toxin:
enterotoxins
bacillus cereus
what bacteria is associated with the following:
causes listeriosis in humans
meningitis
stillbirth
death
animals
spontaneous abortions
meningitis
found in the environment
soil, water
normal flora, humans
intestines, vagina
listeria monocytogenes
what bacteria is associated with the following:
grows on most routine media
resembles group B strep on BAP
colonies are small, white/grey with small zone of beta hemolysis
listeria monocytogenes
which bacteria displays tumbling motility (end over end) on wet mount at room temperature (25°C) and very little at 37°C?
listeria monocytogenes

which bacteria can depict umbrella motlity in semi-solid media at room temperature (25°C)?
listeria monocytogenes
listeria monocytogenes is catalase ____.
positive
listeria monocytogenes is bile esculin ____.
positive
listeria monocytogenes hippurate hydrolysis ____.
positive

listeria monocytogenes is CAMP ____.
positive
in regards to listeriosis, which intrauterine transmission refers to when a fetus often stillborn has disseminated abscesses and/or granulomas?
granulomatous infantseptica
listeria monocytogenes can prefer ____ temperatures.
cold
what condition can be transmitted in the following ways:
foodborne
intrauterine
granulomatous infantseptica
puerperal (post-childbirth)
exposed through vaginal colonization
listeriosis
a “foodborned disease outbreak” refers to when ____ or more people get the same illness from the same contaminated food or drink.
two
listeria monocytogenes and group B streptococcus both have a small zone of ____ on BAP.
beta hemolysis
listeria monocytogenes and group B streptococcus are both hippurate hydrolysis ____.
positive
listeria monocytogenes and group B streptococcus are both CAMP ____.
positive
listeria monocytogenes or group B streptococcus: gram stains GPR (diphtheroid) → coccoid?
listeria monocytogenes
listeria monocytogenes or group B streptococcus: gram stains GPC, pairs and chains?
group B streptococcus
listeria monocytogenes or group B streptococcus: bile esculin negative?
group B streptococcus
listeria monocytogenes or group B streptococcus: catalase negative?
group B streptococcus
listeria monocytogenes or corynebacterium: gamma (non-hemolytic) on BAP?
corynebacterium
listeria monocytogenes or corynebacterium: motile at 25°C?
listeria monocytogenes
listeria monocytogenes or corynebacterium: bile esculin negative?
corynebacterium
which bacteria is associated with the following information:
primarily infects animals, especially pigs
human generally get infected through animal contact or contact with infected animal products
occupational exposure
consuming infected meat (rare)
erysipelothrix rhusiopathiae
erysipelothrix rhusiopathiae can be associated with cellulitis with erysipeloid lesions that can resemble erysipelas caused by which bacteria?
streptococcus pyogenes
erysipelothrix rhusiopathiae are GPR that are highly ____ (various shapes) and non-spore forming.
pleomorphic
lactobacillus is the normal flora of the ____.
genitourinary tract
which species of lactobacillus refers to “doderlein’s bacteria” and is common in vagina because they use glycogen → lactic acid?
lactobacillus acidophilus

what bacterial genus has the following characteristics:
gram stain: medium-long GPR in chains, but variable
colony on BAP: looks alpha hemolytic (can resemble alpha-strep)
most are microaerophilic, but some are facultative anaerobes or anaerobic (can be groups with anaerobes)
lactobacillus
lactobacillus are catalase ____.
negative
lactobacillus are non-motile. true or false?
true
which bacteria are strictly anaerobic/microaerophilic and are normal normal inhabitants of the GI tract in humans/animals (from oropharynx → lower bowel)?
actinomyces
which bacteria presents as GPR, filamentous that tend to branch and may fragment in coccobacilliary or coccoid forms (irregular staining)?
actinomyces
what refers to a yellow-orange granules of intertwined actinomyces filaments solidified with elements of tissue exudate in pus?
sulfur granules
most human actinomycosis is caused by which bacteria?
actinomyces israelii